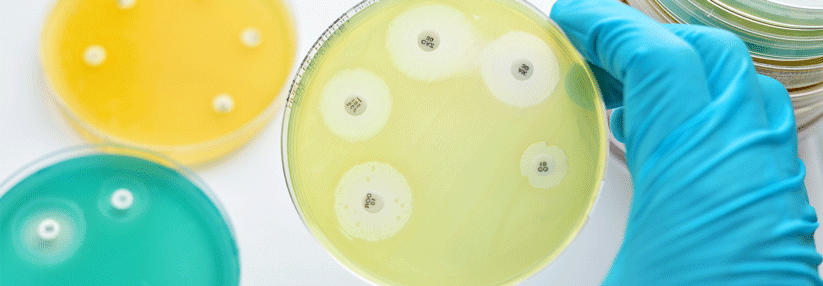

Penicillinallergie – Echte Gefahr oder Einbildung?
 Wie sich eine Penicillinallergie sichern lässt.
© fotolia/Grycaj
Wie sich eine Penicillinallergie sichern lässt.
© fotolia/Grycaj
Als Risikofaktor für eine Penicillinallergie gilt die häufige Exposition gegenüber diesen Antibiotika. Auch höheres Lebensalter und weibliches Geschlecht sollen die Entwicklung einer Allergie fördern, reflektieren aber evtl. nur den vermehrten Antibiotikagebrauch in diesen Kollektiven, schreiben Experten des Drug and Therapeutics Bulletins, London.
Zwei Verlaufstypen der Penicillin-Allergie werden unterschieden:
1. Reaktionen vom Soforttyp beginnen in der Regel innerhalb von 60 Minuten nach dem Allergenkontakt, spätestens nach ein bis sechs Stunden. Sie manifestieren sich mit den üblichen Symptomen einer IgE-vermittelten Allergie – von Pruritus und Urtikaria bis zur Anaphylaxie.
2. Die…
Bitte geben Sie Ihren Benutzernamen und Ihr Passwort ein, um sich an der Website anzumelden.